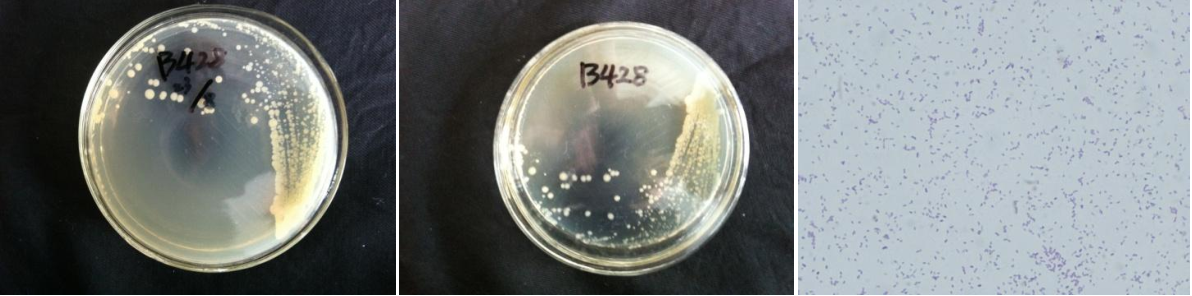

Loading...
| StrainNO | B428 |
| Classification | Aeromonas |
| 16s rDNA sequence | TGCAAGTCGAGCGGCAGCGGGAAAGTAGCTTGCTACTTTTGCCGGCGAGCGGCGGACGGGTGAGTAATGCCTGGGGATCTGCCCA GTCGAGGGGGATAACAGTTGGAAACGACTGCTAATACCGCATACGCCCTACGGGGGAAAGGAGGGGACCTTCGGGCCTTTCGCGA TTGGATGAACCCAGGTGGGATTAGCTAGTTGGTGGGGTAATGGCTCACCAAGGCGACGATCCCTAGCTGGTCTGAGAGGATGATC AGCCACACTGGAACTGAGACACGGTCCAGACTCCTACGGGAGGCAGCAGTGGGGAATATTGCACAATGGGGGAAACCCTGATGCA GCCATGCCGCGTGTGTGAAGAAGGCCTTCGGGTTGTAAAGCACTTTCAGCGAGGAGGAAAGGTTGGCGCCTAATACGTGTCAACT GTGACGTTACTCGCAGAAGAAGCACCGGCTAACTCCGTGCCAGCAGCCGCGGTAATACGGAGGGTGCAAGCGTTAATCGGAATTA CTGGGCGTAAAGCGCACGCAGGCGGTTGGATAAGTTAGATGTGAAAGCCCCGGGCTCAACCTGGGAATTGCATTTAAAACTGTCC AGCTAGAGTCTTGTAGAGGGGGGTAGAATTCCAGGTGTAGCGGTGAAATGCGTAGAGATCTGGAGGAATACCGGTGGCGAAGGCG GCCCCCTGGACAAAGACTGACGCTCAGGTGCGAAAGCGTGGGGAGCAAACAGGATTAGATACCCTGGTAGTCCACGCCGTAAACG ATGTCGATTTGGAGGCTGTGTCCTTGAGACGTGGCTTCCGGAGCTAACGCGTTAAATCGACCGCCTGGGGAGTACGGCCGCAAGG TTAAAACTCAAATGAATTGACGGGGGCCCGCACAAGCGGTGGAGCATGTGGTTTAATTCGATGCAACGCGAAGAACCTTACCTGG CCTTGACATGTCTGGAATCCTGCAGAGATGCGGGAGTGCCTTCGGGAATCAGAACACAGGTGCTGCATGGCTGTCGTCAGCTCGT GTCGTGAGATGTTGGGTTAAGTCCCGCAACGAGCGCAACCCCTGTCCTTTGTTGCCAGCACGTAATGGTGGGAACTCAAGGGAGA CTGCCGGTGATAAACCGGAGGAAGGTGGGGATGACGTCAAGTCATCATGGCCCTTACGGCCAGGGCTACACACGTGCTACAATGG CGCGTACAGAGGGCTGCAAGCTAGCGATAGTGAGCGAATCCCAAAAAGCGCGTCGTAGTCCGGATCGGAGTCTGCAACTCGACTC CGTGAAGTCGGAATCGCTAGTAATCGCGAATCAGAATGTCGCGGTGAATACGTTCCCGGGCCTTGTACACACCGCCCGTCACACC ATGGGAGTGGGTTGCACCAGAAGTAGATAGCTTAACCTTCG |
| Strain Morphology Photos | |
| Morphological Description | Colony round;milky white;steam bun shaped;edge neatly;slippy;sticky;Bacteriophage Rod-shaped;no spore |